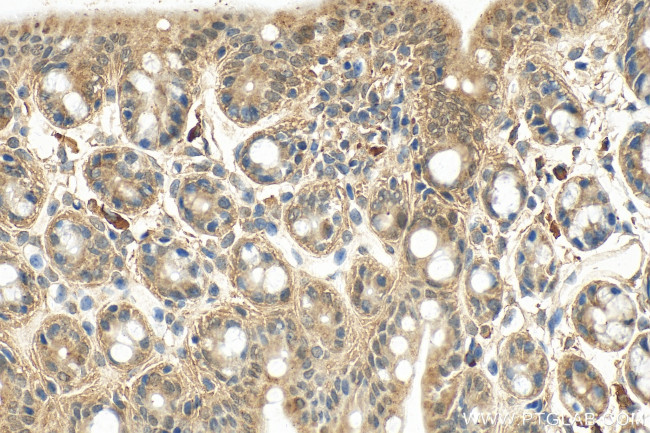
EGLN3/PHD3 Antibody in Immunohistochemistry (Paraffin) (IHC (P))

Search
Proteintech
EGLN3/PHD3 Polyclonal Antibody
{{$productOrderCtrl.translations['antibody.pdp.commerceCard.promotion.promotions']}}
{{$productOrderCtrl.translations['antibody.pdp.commerceCard.promotion.viewpromo']}}
{{$productOrderCtrl.translations['antibody.pdp.commerceCard.promotion.promocode']}}: {{promo.promoCode}} {{promo.promoTitle}} {{promo.promoDescription}}. {{$productOrderCtrl.translations['antibody.pdp.commerceCard.promotion.learnmore']}}
产品信息
27875-1-AP
种属反应
宿主/亚型
分类
类型
抗原
偶联物
形式
浓度
规格
纯化类型
保存液
内含物
保存条件
运输条件
产品详细信息
Immunogen sequence: MPLGHIMRLD LEKIALEYIV PCLHEVGFCY LDNFLGEVVG DCVLERVKQL HCTGALRDGQ LAGPRAGVSK RHLRGDQITW IGGNEEGCEA ISFLLSLIDR LVLYCGSRLG KYYVK
靶标信息
Cellular oxygen sensor that catalyzes, under normoxic conditions, the post-translational formation of 4-hydroxyproline in hypoxia-inducible factor (HIF) alpha proteins. Hydroxylates a specific proline found in each of the oxygen-dependent degradation (ODD) domains (N-terminal, NODD, and C-terminal, CODD) of HIF1A. Also hydroxylates HIF2A. Has a preference for the CODD site for both HIF1A and HIF2A. Hydroxylation on the NODD site by EGLN3 appears to require prior hydroxylation on the CODD site. Hydroxylated HIFs are then targeted for proteasomal degradation via the von Hippel-Lindau ubiquitination complex. Under hypoxic conditions, the hydroxylation reaction is attenuated allowing HIFs to escape degradation resulting in their translocation to the nucleus, heterodimerization with HIF1B, and increased expression of hypoxy-inducible genes. EGLN3 is the most important isozyme in limiting physiological activation of HIFs (particularly HIF2A) in hypoxia. Also hydroxylates PKM in hypoxia, limiting glycolysis. Under normoxia, hydroxylates and regulates the stability of ADRB2. Regulator of cardiomyocyte and neuronal apoptosis. In cardiomyocytes, inhibits the anti-apoptotic effect of BCL2 by disrupting the BAX-BCL2 complex. In neurons, has a NGF-induced proapoptotic effect, probably through regulating CASP3 activity. Also essential for hypoxic regulation of neutrophilic inflammation. Plays a crucial role in DNA damage response (DDR) by hydroxylating TELO2, promoting its interaction with ATR which is required for activation of the ATR/CHK1/p53 pathway. Target proteins are preferentially recognized via a LXXLAP motif.
仅用于科研。不用于诊断过程。未经明确授权不得转售。
篇参考文献 (0)
生物信息学
蛋白别名: Egl nine homolog 3; FLJ21620; HIF-PH3; HIF-prolyl hydroxylase 3; HPH-1; HPH-3; Hypoxia-inducible factor prolyl hydroxylase 3; MGC125998; MGC125999; P4H3; PHD3; Prolyl hydroxylase domain-containing protein 3; Prolyl hydroxylase EGLN3; SM-20; unnamed protein product
基因别名: 2610021G09Rik; AI505553; AI648162; EGLN3; Hif-p4h-3; HIFP4H3; HIFPH3; PHD3; SM-20
UniProt ID: (Human) Q9H6Z9, (Mouse) Q91UZ4
Entrez Gene ID: (Human) 112399, (Mouse) 112407